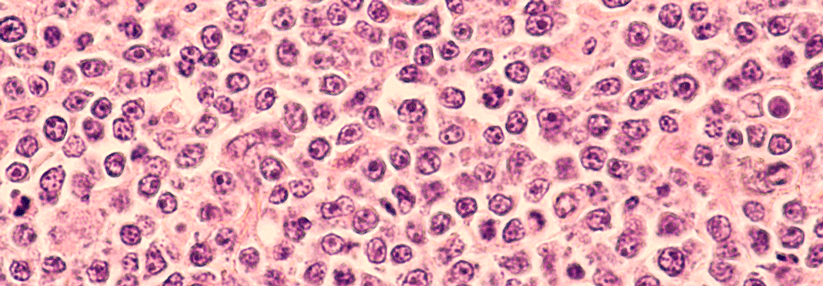

r/r follikuläres Lymphom Stark vorbehandelte Patient:innen erreichen eine CR
 Ein bispezifische Antikörper erwies sich bei Patient:innen mit rezidiviertem/refraktärem follikulärem Lymphom als wirksam.
© Romolo Tavani – stock.adobe.com
Ein bispezifische Antikörper erwies sich bei Patient:innen mit rezidiviertem/refraktärem follikulärem Lymphom als wirksam.
© Romolo Tavani – stock.adobe.com
Das follikuläre Lymphom lässt sich bislang nicht heilen und das progressionsfreie Intervall wird mit jeder Behandlungslinie kürzer. Patient:innen, die nach Versagen einer CAR-T-Zell-Therapie und von bispezifischen T-Zell-Engagern (TCE) rezidiviert oder refraktär sind, stehen nur wenige Optionen zur Verfügung. Hinzu kommt, dass der Zugang zu CAR-T-Zellen limitiert ist und sie erhebliche Toxizitäten aufweisen können. Zudem geht den Lymphomzellen häufig das CD20-Antigen, das die meisten bisherigen bispezifischen Antikörper erkennen, verloren.
Der neue TCE TNB-486 ist mit zwei Antikörperfragmenten ausgestattet, die an CD19 auf B-Zellen und an CD3 auf T-Lymphozyten binden. Mit seiner relativ…
Bitte geben Sie Ihren Benutzernamen und Ihr Passwort ein, um sich an der Website anzumelden.